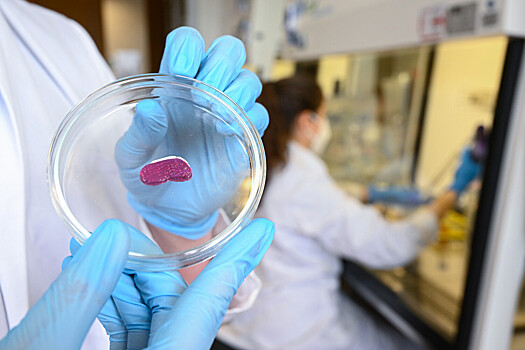
Ученые объявили о прорыве в создании дешевого «мяса из пробирки»

NatFood: стабильное производство решит проблему стоимости культивируемого мяса
Израильские ученые из Еврейского университета в Иерусалиме заявили, что нашли первый экономически эффективный метод выпуска культивируемого мяса — мышечных волокон, выращиваемых в искусственной среде. Исследование опубликовано в научном журнале Nature Food (NatFood).
Команда изучила метод тангенциальной поточной фильтрации для непрерывного производства животных белков.
Новая сборка биореактора позволила расширять биомассу до 130 млрд клеток на литр, достигая выхода 43% веса на объем.
Процесс проводился непрерывно в течение 20 дней, что позволяло собирать биомассу ежедневно.
Кроме того, исследование представило среду без компонентов животного происхождения по цене всего $0,63 за литр, которая поддерживает долгосрочную культуру куриных клеток высокой плотности.
Такой непрерывный метод производства может значительно снизить стоимость и сложность производства культивируемого мяса, потенциально приближая его к повседневным потребителям.
Используя эмпирические данные, ученые провели технико-экономический анализ условного производственного объекта объемом 50 тыс. литров. Расчеты показали, что стоимость производства выращиваемой курицы теоретически может быть снижена до $6,2 за фунт (450 граммов), что соответствует цене органической курицы.
Ранее биологи создали искусственный жир для производства «мяса из пробирки».